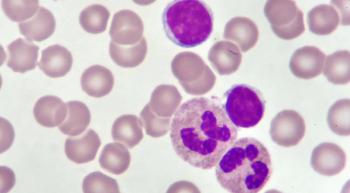

Patients and their doctors should discuss survivorship issues – such as anxiety and fertility issues – sooner rather than later.

Brielle Benyon, Assistant Managing Editor for CURE®, has been with MJH Life Sciences since 2016. She has served as an editor on both CURE and its sister publication, Oncology Nursing News. Brielle is a graduate from The College of New Jersey. Outside of work, she enjoys spending time with family and friends, CrossFit and wishing she had the grace and confidence of her toddler-aged daughter.
Follow Brielle on Twitter @Brielle_Benyon.

Patients and their doctors should discuss survivorship issues – such as anxiety and fertility issues – sooner rather than later.

Dr. Sally J. York goes over the types of immunotherapy-related side effects, and what patients with lung cancer and their caregivers should look out for.

Advancements in the diagnosis and staging of multiple myeloma continue to shape treatment decisions and improve outcomes.

Approximately half of the patients with breast cancer who failed anti-nausea or vomiting therapy for chemotherapy-induced nausea/vomiting during their first cycle of treatment failed to avoid the side effect at some point during the next three treatment cycles.

Patients with aggressive lymphomas experienced sharp increases in quality of life from time of diagnosis until one year later and continued to see improvements for almost a decade.

Doctors told Maryland Governor Larry Hogan to go home and rest after undergoing cancer surgery. But he had other plans: sharing his health issues.

Outcomes for patients with Hodgkin lymphoma continue to improve, thanks to new drugs, according to Dr. Pamela Allen.
New treatment options are outperforming the “old-fashioned” chemotherapy regimens for patients with CLL and SLL, according to Dr. Locke J. Bryan.

Not everyone with myeloma needs to be treated right away, but when they do, there are some important upfront considerations for patients and providers.

CAR-T cell therapy is drastically improving outcomes for patients with diffuse large B-cell lymphoma. However, the treatment can come with some severe side effects that patients need to know about.

Prostate cancer treatment can be detrimental to bone and muscle health, but an exercise regimen and healthy eating habits can help.

Everyone has a role to play in decreasing Clostridioides difficile infection rates on oncology units, recent research shows.

Recent study results demonstrated that there was contamination of popular chemotherapy agents in both patient and staff bathrooms of a cancer center.

A weekly high dose of chemotherapy did not improve survival for patients with epithelial ovarian cancer, though the treatment regimen was effective and well-tolerated.

Finding the best care team can make all the difference for patients with diseases like multiple myeloma.

Clinical trials lead to new cancer treatments — and can give a patient access to effective drugs years before they’re made available to the public.

CAR-T Cell therapy is expanding in the field of blood cancers, but it comes with a host of side effects patients need to look out for. One study is looking to get ahead of the side effect curve for patients about to undergo CAR-T cell therapy.

An oncology nurse outlines ways that patients can prevent dental erosion after a vomiting episode.

Supreme Court Justice Ruth Bader Ginsburg died after five bouts with cancer.

Patients with cancer have been encouraged to reach out to legislators and share their personal stories and advocate for why they think continued funding is important to further cancer research.

Ethan Zohn, "Survivor: Africa" winner, discusses how his winner’s mentality helped him through treatment and how leaning on others has been key in survivorship.

U.S. Supreme Court Justice Ruth Bader Ginsburg, 87, has announced that she is currently undergoing chemotherapy for a cancer recurrence.

The Food and Drug Administration has had a busy couple of weeks, approving new agents to treat a variety of cancers. Here are five recent approvals that patients with cancer may have missed.

“Anyone who met my mother was touched by her spirit. She challenged people to be curious, to seek more, to learn more and to challenge themselves,” LaTour’s daughter, Kirtley Perkins, wrote on Facebook.

Patients participating in phase 1 clinical trials could benefit from the integration of palliative care, according to data presented at the 2020 ASCO Virtual Scientific Meeting.

Results from an early-phase trial showed that cirmtuzumab plus Imbruvica is safe and efficacious in treating patients with relapsed/refractory MCL and CLL.

Precision medicine is improving outcomes for aggressive types of lymphomas, such as mantle cell lymphoma.

The Food and Drug Administration approved Koselugo to treat pediatric patients aged 2 years or older with neurofibromatosis type 1, a rare genetic disorder that causes tumors to grow on nerves.

Patients and their loved ones should take certain precautions to protect themselves from the coronavirus, according to the CDC.

The needs of patients with cancer, their caregivers and care teams remains a “top priority,” according to the FDA.